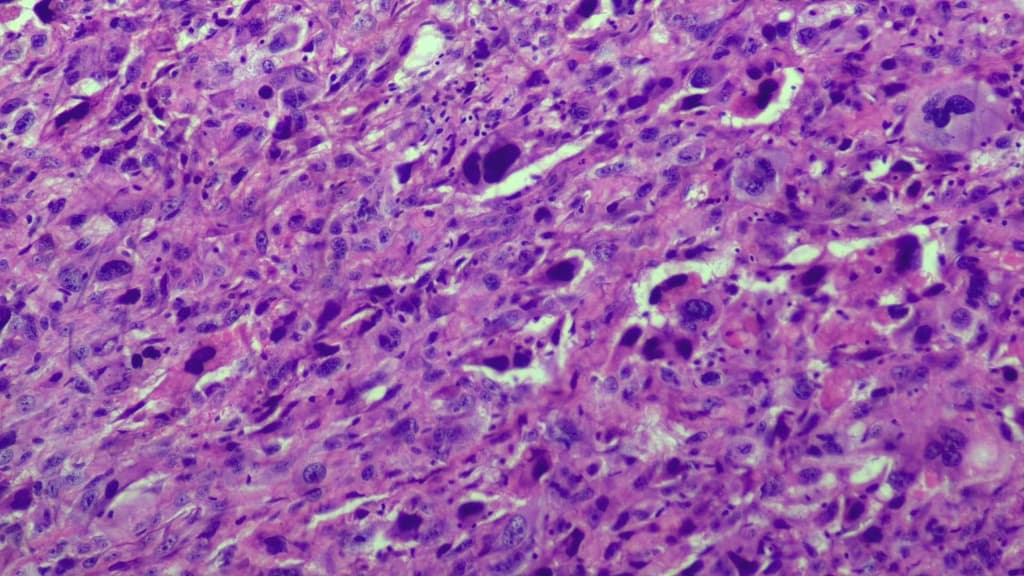
Calcaneal Osteosarcoma (U xương ác tính xương gót chân)

Thu, Apr 9
AI Trực tuyến
Series (3)
Axial C+ arterial phase

CT•Axial C+ arterial phase•1 / 427
Ca bệnhDi căn phổi vôi hóa – u sụn xương
Di căn phổi vôi hóa – u sụn xương
Nguồn gốc
Dữ liệu bệnh nhân
Tuổi30 year
Giới tínhMale
Bệnh sử lâm sàng
Tiền sử điều trị ung thư, chụp X-quang ngực theo dõi tái khám.
Chẩn đoán & Phát hiện
- Khối hình bầu dục ở thuỳ trên bên trái, các hình ảnh còn lại bình thường.
- Khối ở thuỳ trên bên trái, vị trí trong trung thất, có vôi hóa một phần, tiếp giáp với màng phổi trung thất và động mạch dưới đòn trái, không có xâm lấn hoặc bao quanh mạch máu (no invasion or vascular encasement).
- Nốt mô mềm không vôi hóa liền kề (adjacent non-calcified soft tissue nodule).
DISCUSSION:
Ca lâm sàng này thể hiện cả di căn phổi có vôi hóa và không vôi hóa từ u sụn xương chi (appendicular osteosarcoma).
Chẩn đoán
Di căn phổi vôi hóa – u sụn xương (calcified lung metastasis - osteosarcoma)
Chẩn đoán phân biệt
- 1.Di căn phổi từ ung thư nguyên phát khác
- 2.Khối nốt phổi vôi hóa
Điểm giảng dạy
- "Di căn phổi có thể có vôi hóa hoặc không vôi hóa"
- "U sụn xương là một loại ung thư nguyên phát có thể di căn đến phổi"
Thảo luận
Ca lâm sàng này thể hiện cả di căn phổi có vôi hóa và không vôi hóa từ u sụn xương chi. Sự hiện diện của vôi hóa trong tổn thương di căn gợi ý về nguồn gốc u sụn xương. Nốt mô mềm không vôi hóa liền kề với khối vôi hóa có thể là một tổn thương di căn khác hoặc một quá trình lành tính.